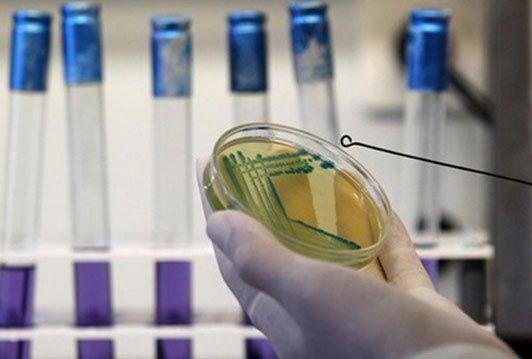
BiH nema u planovima FVO inspektora

29.01.2013 |
EU / POLITIKA
Izvor: Oslobođenje
BiH nije na zvaničnoj listi posjeta misije Ureda za hranu i veterinarstvo Evropske unije, takozvane FVO inspekcije, za 2013, a od njihove ocjene zavisi izvoz proizvoda životinjskog porijekla u Hrvatsku kada ova zemlja 1. jula ove godine postane članica Unije,.
*Pri preuzimanju teksta s portala Akta.ba potrebno je navesti izvor i linkovati tekst.
Dojavi vijest na viber +387 60 331 55 03 ili na mail urednik@akta.ba.